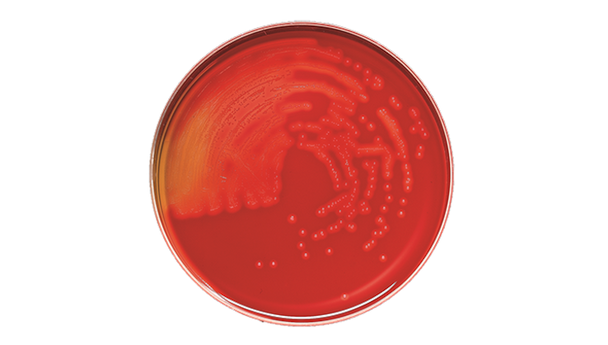
BD BBL Trypticase Soy Agar with 5% Sheep Blood Plate – 100 Plates, 105-Day Shelf Life, Prepared Culture Media
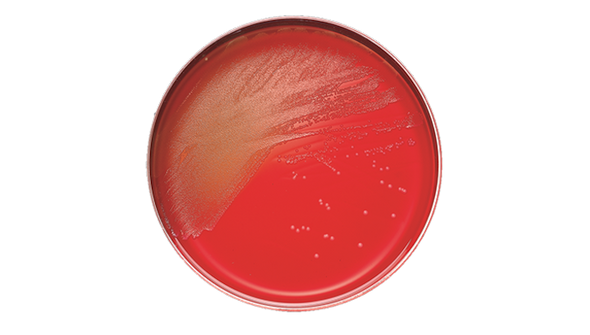
BD BBL Columbia CNA Agar with 5% Sheep Blood Plate – 100 Plates, 84-Day Shelf Life, Prepared Culture Media

Description
BD BBL Trypticase Soy Agar with 5% Sheep Blood Plate is designed for laboratories that require reliable media for cultivating fastidious microorganisms. When accuracy and consistency are essential for clinical or research microbiology, this prepared culture media supports clear results and dependable workflows. Ideal for microbiology labs and diagnostic centers, the 100-plate pack ensures you have a steady supply for routine testing.
- 5% Sheep Blood Enrichment – Promotes the growth of fastidious organisms, supporting precise diagnostic outcomes.
- Modified TSA II Formula – Enhanced formulation allows for recovery and cultivation of a broad range of microorganisms, giving you confidence in your results.
- Clearly Defined Hemolysis Zones – Enables easy identification of hemolytic activity, helping streamline your workflow.
- Large Colony Sizes – Facilitates easier observation and handling, making daily lab routines more efficient.
- Pack of 100 Plates – Provides ample supply for high-throughput environments, reducing the need for frequent reordering.
Prepared Culture Media for Reliable Microbiology Results
This prepared culture media is formulated to deliver consistent performance in the recovery and cultivation of fastidious microorganisms. The inclusion of 5% sheep blood supports the growth of a wide variety of bacteria, while the modified TSA II base ensures larger colony sizes and clearly defined hemolysis zones. Designed for use in clinical and research laboratories, this product helps streamline your workflow and supports accurate diagnostic processes. With a 105-day shelf life, you can rely on this media for ongoing testing needs. The 100-plate pack is ideal for labs that require a dependable supply for routine and high-volume testing.
Features and Benefits
Enhanced Microbial Growth
- 5% Sheep Blood Supplementation – Supports the cultivation of fastidious bacteria for comprehensive testing.
- Optimized TSA II Base – Provides nutrients for robust colony development, improving observation and analysis.
Diagnostic Clarity
- Clearly Defined Hemolysis – Enables precise identification of hemolytic reactions, aiding in accurate diagnostics.
- Large Colony Formation – Makes it easier to observe and handle cultures during laboratory procedures.
Laboratory Efficiency
- 100-Plate Packaging – Reduces restocking frequency and supports high-throughput workflows.
- Ready-to-Use Format – Saves preparation time, allowing staff to focus on essential testing tasks.
Product Specifications
General Information
- Category: Prepared culture media
- Plates Per Pack: 100
- Shelf Life: 105 days
Identification and Packaging
- SKU: 221261
- GTIN (Each): 00382902212614
- GTIN (Bag): 10382902212611
- GTIN (Shelfpack): 30382902212615
- GTIN (US Standard Pallet): 60382902212616
Explore More: See all Prepared Culture Media | Shop more BD BBL Products
Consistent Results and Laboratory Confidence
Choose this prepared culture media for its proven ability to support the growth and identification of a broad spectrum of microorganisms. The enhanced TSA II formula and 5% sheep blood enrichment set it apart from standard media, offering clear hemolysis zones and larger colonies for easier analysis. With a generous 100-plate pack and a 105-day shelf life, your lab can maintain efficiency and confidence in daily operations.
- Enhanced Microbial Recovery – Modified formula supports a wider range of organisms, helping you achieve more reliable results.
- Diagnostic Efficiency – Clearly defined hemolysis zones simplify interpretation, saving valuable time in busy labs.
- Ample Supply – 100 plates per pack minimize interruptions and keep your workflow steady.
- Trusted Brand – Manufactured by BD BBL, a recognized leader in microbiology solutions.
- Competitive Shelf Life – 105-day shelf life supports ongoing testing needs, outlasting many alternatives.
Frequently Asked Questions (FAQs)
What organisms can be cultivated with this prepared culture media?
This media is designed for the recovery and cultivation of fastidious microorganisms, supporting a broad range of bacteria.
What is the shelf life of the plates?
The shelf life is 105 days, allowing for extended storage and use in laboratory settings.
How many plates are included in each pack?
Each pack contains 100 plates, suitable for routine and high-volume testing.
What makes the TSA II formula different?
The modified TSA II formula enhances recovery and growth of microorganisms, providing larger colonies and clearer hemolysis zones.
Is this product ready to use upon arrival?
Yes, the plates are prepared and ready for immediate use in laboratory workflows.
Can this media be used for diagnostic applications?
Yes, it is suitable for diagnostic microbiology and supports accurate identification of hemolytic activity.
Who manufactures this prepared culture media?
This product is manufactured by BD BBL, a trusted name in microbiology solutions.